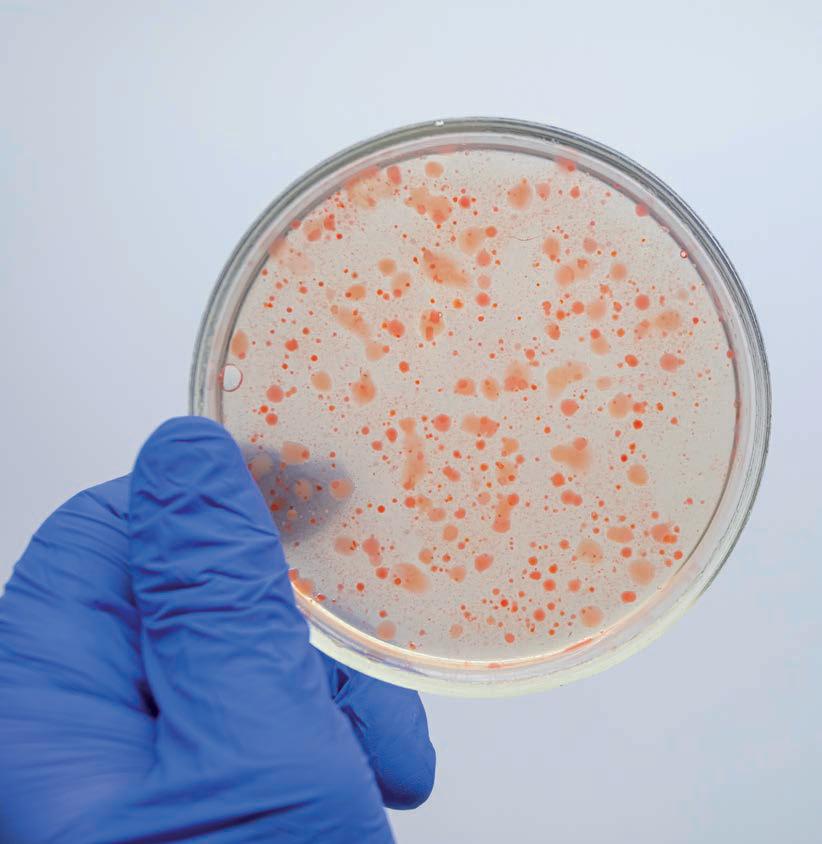

Essayer OR - Gratuit
<> La tarea de la Dra. de la Puerta
INTEGRAL
|Abril 2023
La doctora de la Puerta es médico formada como cirujano plástico, pero circunstancias personales hicieron que, hacia el año 2000, empezara a explorar el mundo fascinante de la microbiota intestinal: <
-

Aprendizaje diario
«No he dejado de estudiar e investigar desde entonces, evolucionando el abordaje de mis pacientes y aplicando a los tratamientos lo que descubro cada día. Es con ellos y de ellos con quien más he aprendido y son ellos los que me animan y motivan para seguir haciéndolo. En la medicina y en la vida, ser flexible me ha permitido caminar recto y nunca darme por vencida, me ha permitido llegar una y otra vez, un poco más lejos».
«La microbiota está desestabilizando el enfoque clásico que tradicionalmente conectaba la salud mental exclusivamente con el cerebro. Hoy sabemos que la cabeza no es nuestro único órgano cognitivo. A día de hoy, hay evidencias que indican que el intestino está permanentemente almacenando información, recordando, sintiendo y pensando por sí mismo».
Las propuestas nutricionales de la Dra. de la Puerta no son vegetarianas, pero creemos que vale la pena escuchar lo que describe en su libro, recientemente publicado*.
«Brindo al lector herramientas sencillas que puede incorporar a su vida cotidiana y que le permitirán optimizar el diálogo permanente de las bacterias con nuestro sistema nervioso, mejorando así su estado de ánimo y su calidad de vida. Abordo aspectos de la salud mental que abarcan, en todas las etapas de la vida, aspectos relacionados con las emociones, la personalidad, la memoria, la relación con la comida, el manejo del estrés, el sueño, etc.».
Nuestro organismo como un todo
Cette histoire est tirée de l'édition Abril 2023 de INTEGRAL.
Abonnez-vous à Magzter GOLD pour accéder à des milliers d'histoires premium sélectionnées et à plus de 9 000 magazines et journaux.
Déjà abonné ? Se connecter
PLUS D'HISTOIRES DE INTEGRAL

INTEGRAL
Granada Una joya mediterránea con poder curativo
Las granadas (Punica granatum) son, como las bautizaron los romanos, malum granatum: la manzana abundante en granos. Esta fruta extraordinaria llega al Mediterráneo desde Persia con los árabes, estableciéndose como símbolo de amor y fecundidad en Oriente y consagrándose a Afrodita en la antigua Grecia, donde ya se conocían sus propiedades afrodisíacas y medicinales.
3 mins
Octubre 2025

INTEGRAL
Yin Yoga El arte de la quietud refrescante
En un mundo obsesionado con la velocidad y la productividad, el Yin Yoga emerge como una invitación radical a la pausa. Esta práctica milenaria, que tiene sus raíces en el yoga taoísta y la medicina tradicional china, representa la polaridad femenina, receptiva y contemplativa del yoga, complementando perfectamente las formas más dinámicas y musculares que dominan las clases occidentales.
2 mins
Octubre 2025

INTEGRAL
Cerebro, amistad y soledad Neuroplasticidad, con Mario Alonso Puig
Neuronas. Hasta hace poco no se sabía que se formaban nuevas conexiones. Solo se perdían conexiones, es decir, el proceso de deterioro a lo largo de los años era absolutamente innegociable, imparable. Hasta que se descubrió la neuroplasticidad. Es decir, la formación de nuevas neuronas a partir de células madre. La formación de nuevos circuitos.
3 mins
Octubre 2025

INTEGRAL
Clavo de olor la pequeña especia con grandes propiedades
Su aroma intenso y sabor picante han conquistado cocinas de todo el mundo, pero el clavo de olor (Syzygium aromaticum) esconde mucho más que su capacidad culinaria. Esta diminuta especia, que no supera el centímetro de longitud, alberga uno de los arsenales terapéuticos más potentes del reino vegetal.
3 mins
Octubre 2025

INTEGRAL
Luces y sombras de la Ley de la Atracción
UNA MIRADA CRÍTICA (PERO RESPETUOSA) AL FENÓMENO QUE HA CAUTIVADO A MILLONES DE PERSONAS
4 mins
Octubre 2025

INTEGRAL
La Manifestación: el arte de cocrear realidades desde la conciencia profunda
Manifestar es hoy una palabra que resuena con fuerza en nuestros tiempos, como un faro que invita a despertar el poder dormido en nuestro interior. Sin embargo, manifestar no es un mero acto de deseo, ni un conjuro mágico al azar. Es un proceso sagrado de alineación entre mente, emoción y energía, una alquimia invisible que nos conecta con la creación misma.
3 mins
Octubre 2025

INTEGRAL
Ensaladas inteligentes para el control de la diabetes
Presentamos el primero de una serie de artículos para adentrarnos en la diabetes, hoy. De nuevo la diabetes como señal, como síntoma de una buena colección de problemas para la salud. Comenzamos con una breve y sencilla introducción y las recetas. En las siguientes entregas iremos avanzando para profundizar en la cuestión.
7 mins
Octubre 2025

INTEGRAL
Sanidad, pantallas y salud
Esta sección nació a raíz de los sucesos e informaciones relacionadas con la intencionalidad de promover un Nuevo Orden Mundial (NOM) autoritario, a raíz de la etapa Covid-19, un experimento falseado como «pandemia». Hoy, más allá de las señales de alerta que da el planeta, existe una flagrante manipulación informativa. No se aborda toda la verdad, de forma contrastada y comprobable, ni mucho menos los movimientos del poder para acercarnos a un cambio político que pretende eliminar buena parte de la libertad natural humana. Esta es la entrega 35 de estas anotaciones.
9 mins
Octubre 2025

INTEGRAL
La ducha consciente y el cuidado natural de la piel
La piel, nuestro órgano más extenso con aproximadamente 1,7 m² de superficie, desempeña funciones vitales que van mucho más allá de la simple protección. Como bien explica la naturópata Margot Helmib, \"la piel envuelve y protege nuestro organismo de las agresiones externas\", pero también regula la temperatura corporal, almacena nutrientes y permite la síntesis de vitamina D mediante la exposición solar.
3 mins
Octubre 2025

INTEGRAL
Esquejes de Otoño: 10 pasos que te convertirán en un maestro de la propagación
El otoño marca el momento perfecto para una de las técnicas más gratificantes de la jardinería ecológica: la multiplicación por esquejes. Esta práctica milenaria no solo te permitirá obtener plantas gratis, sino que conecta con la esencia misma de la agricultura sostenible, donde cada planta puede dar origen a decenas de nuevos ejemplares.
4 mins
Octubre 2025
Translate
Change font size

